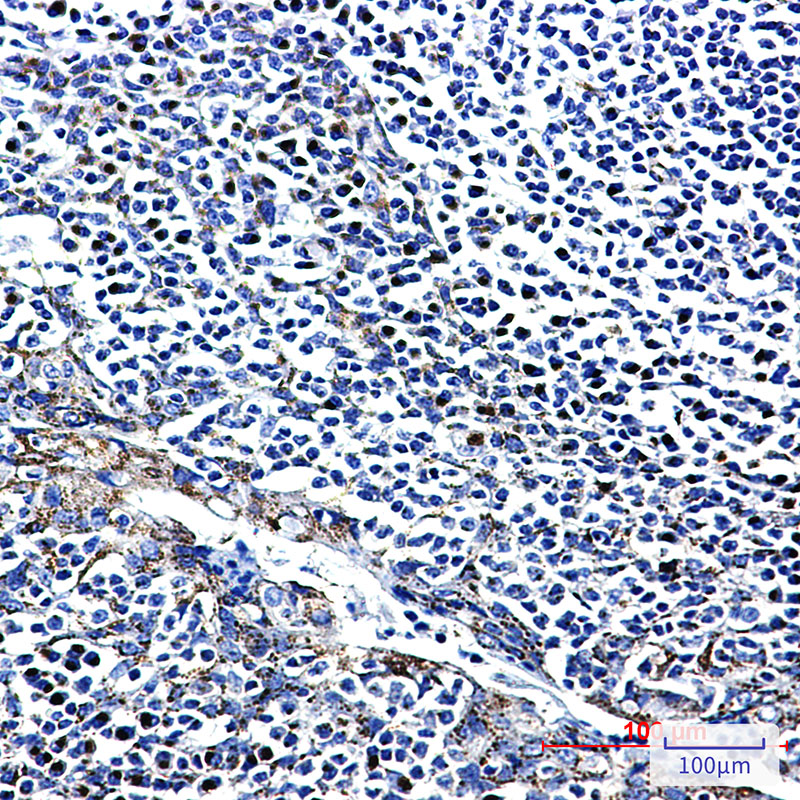

-
分类: 科研抗体货号: P22259别名: ACTR2; ARP2; ARP2/3 COMPLEX应用: WB,IF反应种属: Human,Mouse,Rat
-
分类: 科研抗体货号: P22244别名: ACTL6A; BAF53; BAF53A; INO80K; Actin-like protein 6A; 53 kDa BRG1-associated factor A; Actin-related protein Baf53a; ArpNbeta; BRG1-associated factor 53A; BAF53A; INO80 complex subunit K应用: WB,IP,IF反应种属: Human
-
分类: 科研抗体货号: P22223别名: CAP 2; Adenylyl cyclase-associated protein 2应用: WB,IP反应种属: Human
-
分类: 科研抗体货号: P22258别名: APLP2; APPL2; Amyloid-like protein 2; APLP-2; APPH; Amyloid protein homolog; CDEI box-binding protein; CDEBP应用: WB反应种属: Human,Rat
-
分类: 科研抗体货号: P22243别名: ActR IIB; ACVR 2B; HTX4应用: WB反应种属: Human,Mouse,Rat,Hamster
-
分类: 科研抗体货号: P22222别名: FGFR3; JTK4; Fibroblast growth factor receptor 3; FGFR-3; CD antigen CD333应用: WB,IHC,IF反应种属: Human
-
分类: 科研抗体货号: P22257别名: APC; DP2.5; Adenomatous polyposis coli protein; Protein APC; Deleted in polyposis 2.5应用: WB,IP,IF反应种属: Human
-
分类: 科研抗体货号: P22241别名: Aconitate hydratase; mitochondrial; Aconitase; Citrate hydro-lyase应用: WB,IP,IHC,IF反应种属: Human,Mouse,Rat
-
分类: 科研抗体货号: P22221别名: IL25; IL27; SF20; IL27w; C19orf10; R33729_1; EUROIMAGE1875335应用: WB反应种属: Human
-
分类: 科研抗体货号: P22256别名: ERF1; TFAP2G; hAP-2g; AP2-GAMMA应用: WB,IHC,IF反应种属: Human

鄂公网安备42018502007531号
鄂公网安备42018502007531号

